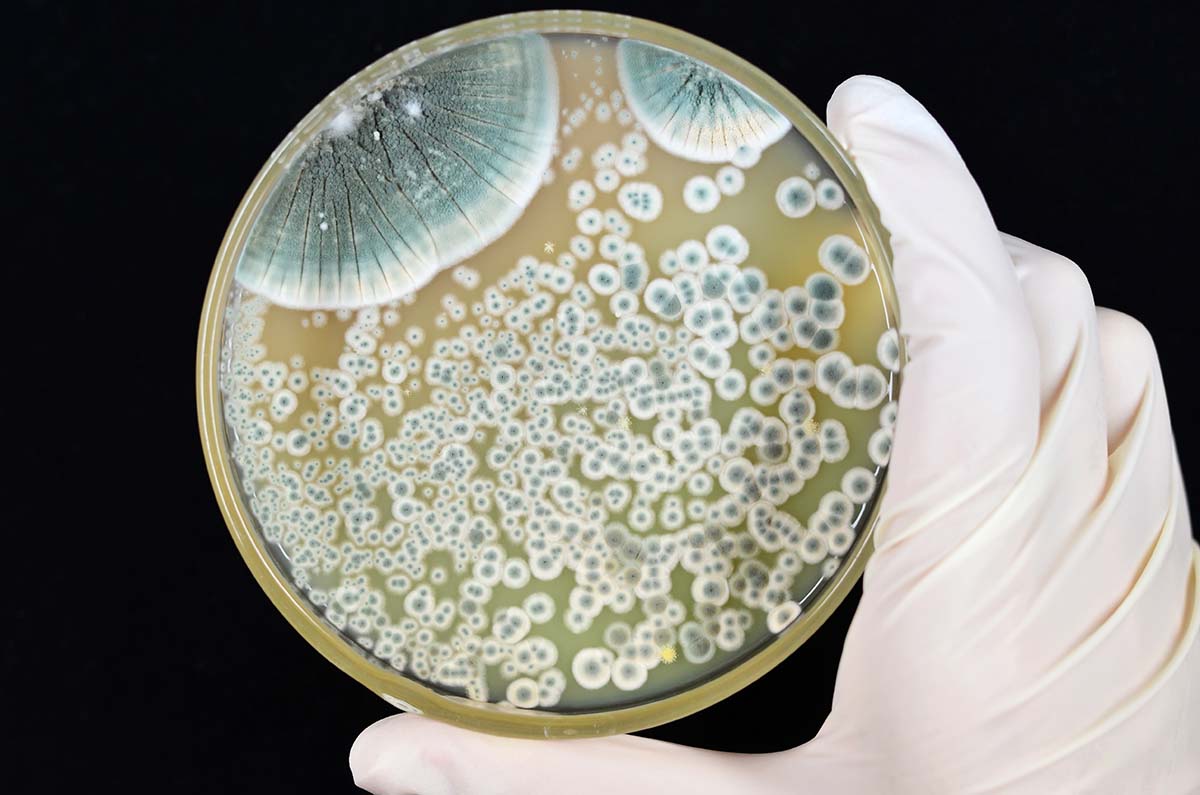

Past, present and future of healthcare and the human body
It’s a healthy thing to reflect on the past to appreciate where we are today; in our own lives, in our professions, and in our world. In terms of medicine and understanding the human body, we have come a long way as a human race. Yvonne Slater from Glasgow Science Centre and Kirsty Earley from The Royal College of Physicians and Surgeons of Glasgow are looking to the past, present and future of healthcare and the human body.
The past paved the way for current and future clinical practice
So much of the past is reflected in current clinical practice, influencing not only the physical, but also the emotional and spiritual components of healthcare. Take it back to the Ancient Greeks with the Hippocratic Oath, an ethical code that many practitioners hold to today, or the theory of antisepsis, which was discovered in Glasgow in 1867 and underpins our understanding of the importance of hygiene. Or how about the discovery of anaesthesia in the mid-1800s, or the foundation of medical imaging through the discovery of X-radiation in 1895? It is through the lens of history that we are able to appreciate these fundamental components of clinical practice on another level. Without the pioneering work of individuals such as Joseph Lister in antisepsis and infection control, Marie Curie in radiation and medical imaging, and William Macewen in brain surgery, we would be stuck in the past where tradition trumped evidence.

Throughout the rapid medical advances of the 20th Century we continued to fight infection, with the discovery of penicillin and further antibiotics, the delivery of effective vaccination programs and an increased understanding of the immune system. We harnessed the potential of radiation therapy and chemotherapy as treatments for cancer and developed new ways to see under the skin and explore the human body with ultrasound, MRI and other non-invasive scanning technologies. We successfully carried out life-saving organ transplants, extended the average human lifespan and moved the focus from surviving disease to keeping healthy.
Global exchange of human knowledge and ideas
The 20th century also brought another change in approach. Increasing access to international travel and rapid worldwide communication meant scientists and clinicians could more easily share ideas and knowledge. Teamwork and collaboration have become vital, moving us away from a focus on individual pioneers. But it is still on their shoulders that we are standing today. We still look to the past to ground us in today and to allow us to glimpse into the future.
DNA, data and digital healthcare
Today, key words in modern healthcare are DNA, data and digital. We can swallow a camera pill and track its progress through the digestive system as it sends back images and data about our gut health. We can train computer algorithms with large amounts of data so that they can quickly analyse and recognise patterns. This application of artificial intelligence will speed up the process of diagnosis and treatment decisions, through the rapid scanning of x-rays and images to accurately detect fractures, certain cancers or acute stroke, for example. The possibilities of personalised medicine are coming ever closer, where having knowledge of patients’ DNA means that treatment can be tailored for the individual, delivering the most appropriate medicine at the right dose and at the right time.

And looking to the future, we are living longer, exploring further. Many of us already use wearable digital devices that track our sleep, our heart rate and level of activity. In future, wearing smart sensors may enable people with long term conditions, and their care team, to more closely monitor their health and allow earlier identification of risks and intervention. With longer lifespans, the use of smart technology, coupled with the advance of personalised medicine will help us support more independent living in later life.
The human body in space
We are planning to return to the Moon and establish long term missions to explore its surface, with the added possibility of sending astronauts from there to Mars. Through studying the health of astronauts, we are learning what happens to the human body after long periods in space and how we might adapt in future. Maybe some of us alive today will spend time living on other planets in the future and will be the ones reflecting on the medical challenges this has brought for the next generation of scientific pioneers to solve.
Further Information
The Royal College of Physicians and Surgeons of Glasgow
This blog post is adapted from an article that first appeared in Glasgow Times in March 2022.
Curious About: The Human Body
You can explore these stories of healthcare and the human body with Glasgow Science Centre’s online festival, Curious About: The Human Body, from 9 – 11 March 2022. Join in live talks or delve into a wealth of activities and videos by visiting the Curious About website.